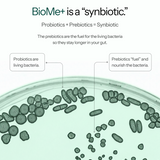
BioMe+

Vegan Certified (Vegan Society)
Allergen-free
Gluten-free
Lactose-free
Non-GMO
Safe
BioMe+ is a synbiotic drink designed for gut and brain health.

Role
Feed beneficial bacteria, improve regularity, and support satiety
Source
Fructooligosaccharides, Inulin

Role
Support gut balance, strengthen the gut-brain axis, and improve mood, sleep & digestion.
Source
Lactobacillus rhamnosus, Lactobacillus helveticus, Bifidobacterium longum, Bifidobacterium animalis, subsp. lactis, Lactiplantibacillus plantarum.

Role
Calms the nervous system, reduces stress sensitivity, and supports restorative sleep.
Source
Magnesium
Testimonials

Backed by science. Built for your brain.
We believe in transparency and scientific rigor. Explore the research behind our formulas, the brain-gut connection, and how your microbiome impacts mood, immunity, and resilience.
Pure. Potent. Proven.
We know what goes into your body matters.
Science based
Gut-brain axis formulated
Certified Vegan
Premium ingredients
Community education
Made in the E.U.
Frequently asked questions about BioMe+
What is BioMe+ and what are the key ingredients?
BioMe+ is a mineral-enriched synbiotic instant drink formulated to support the Gut-Brain-Axis.
Its key ingredients include:
- A blend of five probiotic strains known for their positive effects on gut health, mood, and stress management.
- Lactobacillus rhamnosus
- Lactobacillus helveticus
- Bifidobacterium longum
- Bifidobacterium animalis subsp. Lactis
- Lactiplantibacillus plantarum
- The prebiotics inulin (from chicory root) and fructooligosaccharides (FOS from sugar beet) which promote the growth and activity of beneficial gut bacteria.
- Magnesium (as magnesium glycerophosphate) is included for its high bioavailability and contribution to normal psychological and nervous system functions, as well as reduction of tiredness and fatigue.
- Maltodextrin (from non-GMO corn) acts as a carrier and stabilizer for the probiotics.
How does BioMe+ aim to improve health, particularly concerning the Gut-Brain-Axis?
BioMe+ is designed to improve health by targeting the Gut-Brain-Axis through a combination of probiotics, prebiotics, and magnesium.
This is how BioMe+ works:
- Probiotics contribute to a balanced gut microbiome (eubiosis), which has been linked to improved gastrointestinal well-being, mood, and stress management through various pathways including the vagus nerve, endocrine system, immune system, and the production of short-chain fatty acids (SCFAs).
- Prebiotics support the growth of these beneficial bacteria, enhancing their effects
- Magnesium plays a crucial role in neurological and psychological functions, further supporting the Gut-Brain-Axis.
Clinical studies have indicated that the specific probiotic strains in BioMe+ can positively influence resting state brain function, and psychological symptoms like depression, anxiety, and stress-related gastrointestinal issues.
How do the prebiotics in BioMe+, inulin and fructooligosaccharides (FOS), influence intestinal health?
At BrainGood, research is at the heart of everything we do.
We only select ingredients that have clinically proven efficacy.
This means their benefits have been demonstrated in clinical studies and published in international peer-reviewed journals, meeting the highest scientific standards. You can read the research supporting BioMe+ and its ingredientshere.
We collaborate with theGreen Beat Institute for Nutrient Research, a leading research organization in Austria, to ensure our formulations are based on the latest scientific findings. Green Beat conducts studies on nutritional supplements, publishing its results in peer-reviewed journals, where independent experts evaluate the research for accuracy and credibility.
Through this partnership, BrainGood translates cutting-edge research into effective, science-backed supplements that support the gut-brain-immune axis—helping you feel your best from the inside out.
Why is BioMe+ a powder in a sachet and not in a pill form?
BioMe+ powder is in a sachet, because the amount of prebiotics needed to support the probiotic strains is too large to fit inside a capsule.
The powder format also allows the 30 billion CFUs* of live microorganisms per sachet to be activated with water. This activation is key, as when the probiotic strains are activated, they are stronger and have a better chance of surviving the digestion process.
*CFUs means “colony forming units,” and are a unit of measurement used to determine the number of live bacterial cells.
What does BioMe+ taste like?
It has a neutral and flavorless taste, which is a good thing! The neutral taste allows the powder to easily be mixed with other beverages without changing their flavor.
Why didn’t we add flavor to BioMe+?
We didn’t add any flavors so that BioMe+ is more effective!
By not adding in any flavor ingredients, we maintain the dryness of the formulation. Any additional moisture would reduce the shelf life and stability of the probiotics.
Why do I need to wait 3 minutes before drinking?
The 3-minute activation time in water before drinking helps the microorganisms rehydrate and become active, improving the bacteria’s survival as they pass through the gastrointestinal tract.
What are the quality assurance and safety measures for BioMe+?
BioMe+ undergoes rigorous quality assurance and safety testing. This includes the measurement of pesticides, toxines, heavy metals, and comprehensive microbiological testing for yeasts, molds, and other unwanted microorganisms besides the intended probiotics. These chemical analyses are conducted on each batch immediately after manufacturing, while the microbiological parameters are monitored throughout the entire shelf life.
The concentrations of ingredients are carefully controlled from the time of manufacturing to ensure efficacy and stability throughout the 24-month shelf life. Stability testing demonstrates that over 30 billion viable probiotics remain at the end of this period.
BioMe+ is certified vegan, allergen-free and non-GMO.
Is BioME+ suitable for vegetarians and vegans?
BioMe+ iscertified veganby 3rd party, independent certification with the Vegan Society in the UK. See the certification here.
Is BioME+ non-GMO?
BioMe+ is made with non-GMO ingredients and complies with GMO Regulation EU 1829/2003, and 1830/2003; 7 CFR part 66.
What nutritional claims does BioMe+ have?
BioMe+ meets the following nutritional claims:
- Fat-free
- Saturated fat-free
- Very low sodium/salt
- Source of fiber
- High fiber
- Source of magnesium
How should I take BioMe+ for optimal results?
- For the best results, mix one sachet of BioMe+ with a glass of water or your favorite lukewarm liquid and stir well.
- Let the mixture sit for about 3 minutes to activate the microorganisms, then stir again before drinking.
- Take BioMe+ on an empty stomach to maximize probiotic survival. Ideally, consume it at least two hours before or after a meal.
- Be sure to take the full sachet to ensure an effective dose.
But don’t worry! If you can only take on a full stomach or you eat after taking, you will still have a great effect. Taking it on a full stomach is better than not taking it at all.
Can I mix BioMe+ with any liquid?
We recommend mixing with water for best results, but you could also try coconut water, juices, or milk. For best results, avoid mixing with hot drinks like coffee or tea or acidic drinks like orange juice or carbonated water. Hot beverages or carbonated/acidic drinks can harm the probiotics and make BioMe+ less effective.
How do I store BioMe+?
BioMe+ should be stored at room temperature. No need to refrigerate.
I have allergies, can I take BioMe+?
BioMe+ is allergen-free. This means that the product is gluten-free, lactose-free, soy-free, shellfish-free, nut-free, etc. Therefore, Biome+ does not specifically contain any of the following substances:
- Cereals containing gluten
- Celery and celery products
- Crustaceans/shellfish
- Molluscs
- Egg and egg products
- Fish and fish products
- Lupine and lupine products
- Peanuts
- Sesame seeds
- Soy/soybeans
- Milk and milk products
- Mustard
- Tree nuts and nut products
- Sulphites
If I have food intolerances, can I take BioMe+?
While generally safe for most individuals, BioMe+ contains inulin and fructooligosaccharides (FOS). If you have fructose intolerance or malabsorption, BioMe+ may cause gastrointestinal discomfort such as bloating, gas, and abdominal pain. Therefore, those with known fructose intolerance should consult a healthcare professional before using BioMe+.
Can I take BioMe+ if I am pregnant or breastfeeding?
Although research suggests probiotics are generally safe during pregnancy and breastfeeding, it is always recommended to consult with a healthcare professional before starting any new supplement.
Is BioMe+ suitable for children?
The probiotic strains are typically safe and suitable for children.
Are there any specific warnings orcontraindications associated with BioMe+?
While generally safe for most individuals, according to International Scientific Association for Probiotics and Prebiotics (ISAPP) guidelines, there are certain populations who should exercise caution with probiotics. These are:
- premature infants
- immunocompromised individuals
- those with serious illnesses
- those with “short gut”
If this is the case, please consult with a healthcare provider.